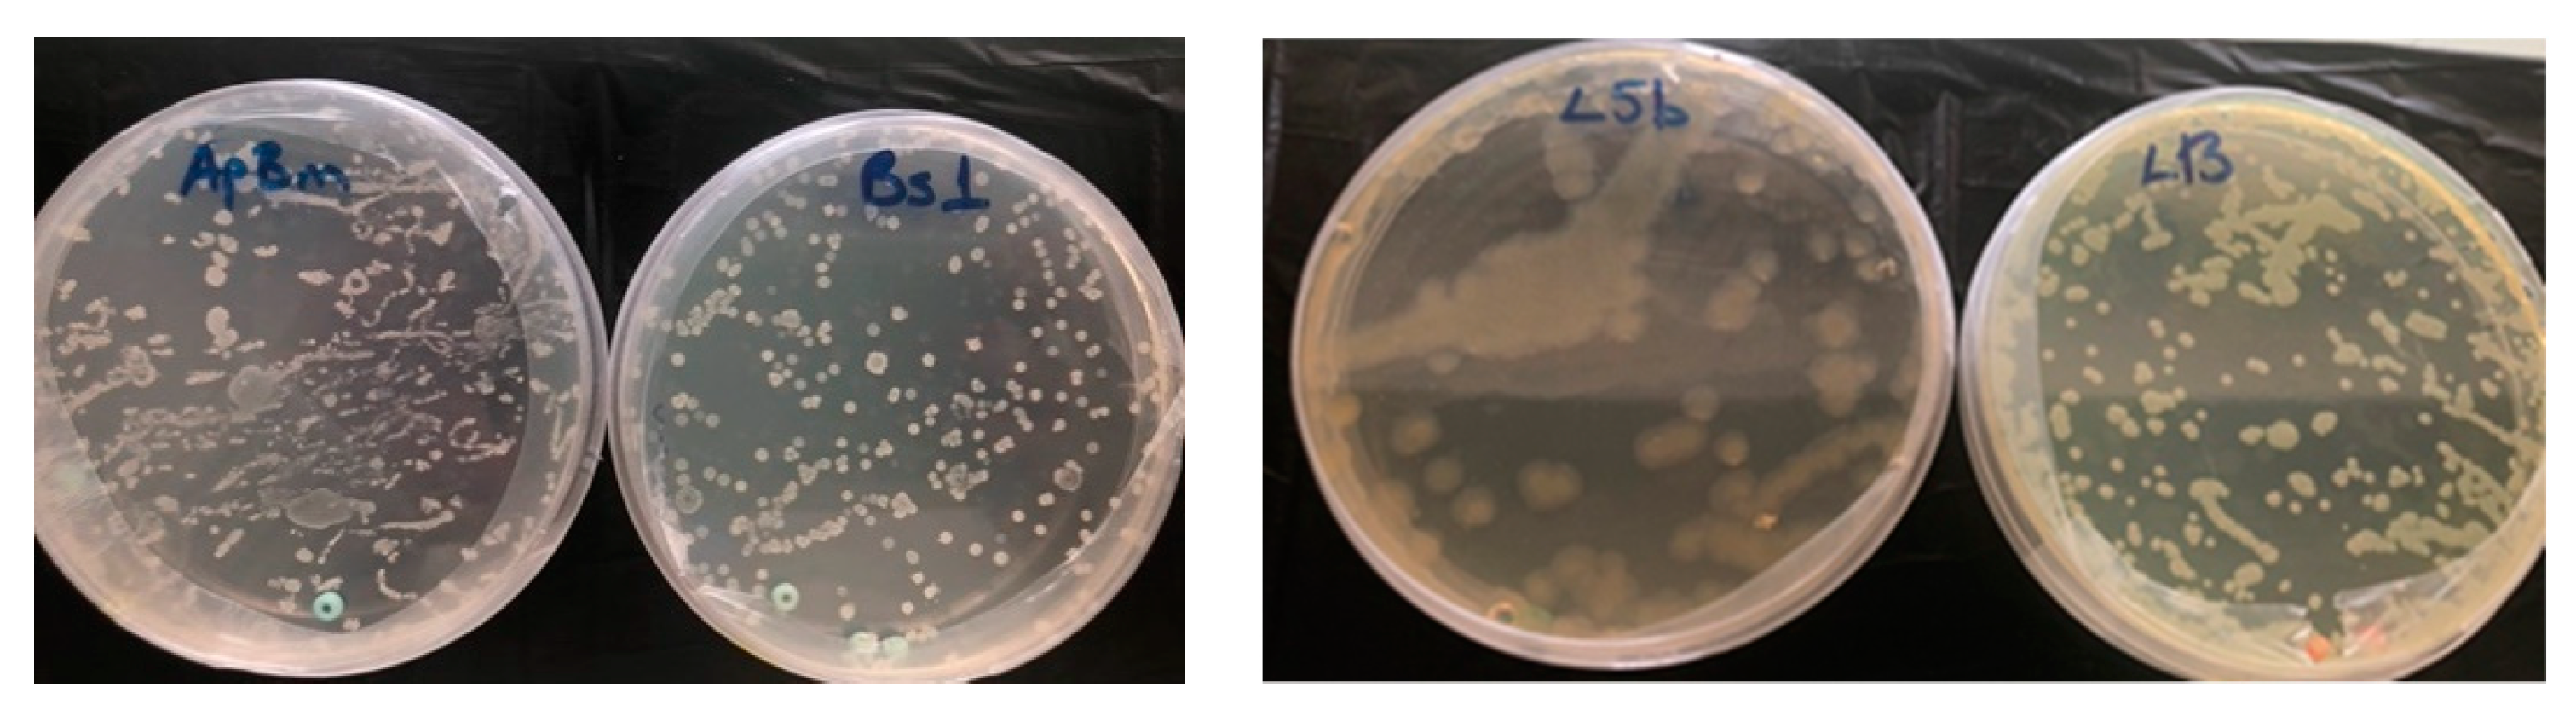
Horticulturae 07 00075 g003 Horticulturae 07 00075 g003

Abstract
Fruit maturity for seed production can occur at various times because of the continual flowering of pepper plants. Accordingly, seeds with different maturity are acquired as the fruits are collected in a single harvest. Immature seeds obtained in this harvest may lead to a decrease in the quality of seed lots. Therefore, this research aimed to evaluate the influence of four different endophytic bacteria strains (Pseudomonas fluorescens strain L5b, Pseudomonas gessardii strain L13, Bacillus subtilis strain Bs1 and Bacillus mojavensis strain ApBm) on germination and seedling vigor of immature and mature bell pepper seeds. To obtain seeds with different maturity levels, fruits were collected 45–49 days after flowering for immature seeds and 65–69 days for mature seeds. The effectiveness of these bacteria strains was examined by coating seeds with four different endophytic bacteria strains separately. Additionally, to see the activity of endophytic bacteria more clearly, a mock treatment with sterile water was added to the experiment as a control (+) group. Bio-priming (especially strain Bs1 and L13) improved germination and seedling emergence characteristics of both immature and mature seed lots compared to control groups (p < 0.05). The results demonstrate that bio-priming with beneficial endophytic bacteria can be used to stimulate the quality of both immature and mature seeds from the pepper.
1. Introduction
Seeds are one of the vital components and the means of gaining high-quality crops, mainly in vegetable production. Detection of suitable harvest time for seed maturity with high quality is crucial for seeds that have high moisture content during development [1]. Pepper (Capsicum annuum L.) seeds keep seed moisture at maturity [2], and high germination percentage is not simply attained because of the subsequent flowering on the mother plant. Consequently, the proper harvest time for fruit maturation influences the pepper seeds’ seed quality [3,4,5], which affects high-quality transplant production in pepper. Moreover, immature pepper seeds need a longer time to germinate and lose quality faster. Hence, improving and preserving seed quality in this species has great importance.
Fruit ripeness can be monitored at varied times owing to the constant blooming of the pepper plant. Eventually, seeds with different maturity levels are acquired in commercial seed production since fruits are generally harvested in once-over harvesting. When seeds of different maturity are collected in one group, immature seeds can adversely impact seedling emergence and uniformity, resulting in a decrease in the quality of seed lots [6]. Correspondingly, if the quality of the immature seeds is improved, it can have a favorable influence on the final quality of the seed lot [7].
Initiation of physiological activity without the emergence of the radicle of seed-by-seed priming has drawn attention in plant production [8]. Numerous priming methods using chemicals were developed to increase seed quality. However, stimulated environmental and health issues along with the immense use of chemicals bring attention to different practices in agriculture. Accordingly, with the recent progress in seed priming techniques, seed bio-priming with beneficial microorganisms has gained attention as a promising method.
Endophytic bacteria are microorganisms living inside plants without creating noxious efficacy [9]. Many endophytic bacteria that are in strong contact with seeds may have adapted to link with embryos or seedlings to regulate seedling growth [10,11,12,13,14] and improve plant growth through enhanced nutrient uptake, nitrogen fixation, synthesis of enzymes, siderophores production and growth phytohormones [15,16,17,18,19]. Bio-priming organisms with PGPB comprise species of the genera Pseudomonas and Bacillus [20,21] along with Burkholderia, Stenotrophomonas, Micrococcus, Rhizobium, and Pantoea, Microbacterium [22,23,24,25,26,27]. The bio-priming method has been studied and described by many researchers [19,28,29,30,31,32,33,34,35,36] in various ways, but it still needs to be discovered and advanced. The method has a significant role in improving germination, seed quality, plant development and yield [37,38]. It was reported that the treatments could stimulate seed germination and uniformity [11,39] and a better stand establishment [40].
Variations in compounds of the bacteria in/on seeds can affect seed vigor. For instance, diminishing the bacterial amount within Setaria viridis seeds leads to a decline in their germination percentage [41]. Furthermore, positive associations among seed bacteria and the mean germination time of Brassica napus were also described [42].
Whereas some studies have focused on the effect of seed microbiota on germination and emergence [43,44,45,46], bacterial communities’ influence on seed enhancement possibilities of differentially matured lots is currently unknown [47,48]. Therefore, the aim of the present study was to evaluate the effects of four different endophytic bacteria, Pseudomonas fluorescens strain L5b, Pseudomonas gessardii strain L13, Bacillus subtilis strain Bs1 and Bacillus mojavensis strain ApBm, on immature and mature pepper seeds by the meaning of quality.
2. Materials and Methods
2.1. Seed Production
The study was performed in 2019 and 2020 in greenhouse conditions of Ataturk Horticultural Central Research Institute—Yalova (latitude 40.7° N, longitude 29.3° E, altitude 8.6 m above sea level). “Kandil Dolma” open-pollinated bell pepper was used as plant material. This cultivar is widely produced and consumed in Turkey and registered to the Atatürk Horticultural Central Research Institute. Therefore, it was chosen as the material in the study (Figure 1).
Figure 1.
Labeled flowers and fruits of cv. “Kandil Dolma” pepper.
Seeds of “Kandil Dolma” pepper were sown in the second week of March 2019. Seedlings were planted in production parcels in the second week of May. The medium used for seedling production was the mixture of 2:1 peat moss (Potgrond P, Germany) and perlite. Plant spacing was 0.7 m between rows and 0.5 m between plants. The trial soil was sandy loam with pH 7.34, EC 2.48, organic matter 3.46% and extractable potassium, phosphorus and lime were 39.41, 10.02 mg kg−1 and 1.42%, respectively. Sample collection and analysis for soil chemical features and nutrient conditions was executed as described in ICARDA [49]. Weekly fertilization was managed based on soil analysis and plant development. 20–20–20 N, P2O5 and K2O kg ha−1 was spread in the parcel by irrigation. Once per week, irrigation was made until July. After this, irrigation was made every three days until the end of August. Furthermore, the mean temperature was 14.8, 18.7, 23.4, 27.5, 28.1, 27.7 and 25.4 °C from March to September during the season.
A total of 120 flowers were labeled (four flowers per plant labeled at the same time) at full anthesis, and fruits were harvested 45–49 (immature) days and 65–69 days (mature) after flowering in the vegetation period. Seeds extracted from the fruits were dried at 25 °C in an incubator for 24 h to obtain about 7–7.5% seed moisture content. Determination of moisture content of dried seeds was done according to the ISTA method [50]. The dried seeds were kept at 4 °C in hermetically laminated aluminum foil packets until use (Figure 2).
Figure 2.
Extracted seeds of pepper and hermetically laminated aluminum foil pack.
2.2. Bacterial Strains and Bio-Priming Treatment
Four strains of endophytic bacteria were chosen in this study, namely, Pseudomonas fluorescens strain L5b, Pseudomonas gessardii strain L13, Bacillus subtilis strain Bs1 and Bacillus mojavensis strain ApBm (Figure 3). They were ensured by the Department of Plant Protection, Faculty of Agricultural at the University of Ankara, Turkey.
Figure 3.
Pure cultures of the endophytic bacteria on King B medium.
The endophytic bacteria Bacillus subtilis (strain Bs1) and Bacillus mojavensis (strain ApBm) were isolated from the inner tissues of apple (Malus domestica) leaves, Pseudomonas fluorescens (strain L5b), and Pseudomonas gessardii (strain L13) were isolated from lettuce (Lactuca sativa) leaves and deposited in the Bacterial culture collection of Ankara University Faculty of Agriculture, Department of Plant Protection. All strains were able to produce siderophores (Canik Orel, unpublished). The strains were identified by the amplification and sequence of the 16S rRNA gene as previously described [51]. Obtained sequences were blasted and submitted to the GeneBank of NCBI under the accession numbers MW_843843-45 and MW_850518.
The experiment was carried out with four treatments and two control groups. The treatments were Bacillus mojavensis (strain ApBm), Bacillus subtilis (strain Bs1), Pseudomonas fluorescens (strain L5b) and Pseudomonas gessardii (strain L13) coated seeds, non-treated (control) and sterile distilled water (control (+))-treated seeds. Bacteria were grown from pure cultures on King B and nutrient–agar plates and then were suspended in sterile distilled water after 24 h of incubation. The bacterial cell suspension was adjusted with a UV-visible spectrophotometer at OD600. Immature and mature “Kandil Dolma” pepper seed lots were surface sterilized with 5% sodium hypochlorite for 60 s. and rinsed three times in sterile distilled water, and then dried overnight on sterile blotting papers. Seeds were coated with endophytic bacteria strains individually. 5 mL of the suspension of each bacterial strain, OD600: 1 × 108 cfu mL−1 inoculums, put into a Petri dish, and 70 mg of carboxymethyl cellulose (CMC) was added as adhesive material. One gram of seed was put into this suspension and treated with the endophytic bacteria suspension at 27 °C for 3 h in a shaker incubator, then placed in sterile Whatman filter papers and dried at room temperature overnight in the laminar flow hood. Untreated seeds were considered as control. Apart from that, mock treatment with sterile water was added to the experiment as a control (+) group. This group aimed to reveal the effectiveness of endophytic bacteria rather than the priming effect on the quality of pepper seeds by placing the seeds in sterile water instead of the bacterial solution.
2.3. Germination Experiment
The trial was conducted with 4 replicates, and each replicate had 50 seeds for each endophytic bacteria and control groups (i.e., 4 endophytic bacteria, control (+) and control). Two pieces of Whatman No: 1 blotting paper were placed in 9 cm Petri dishes. Then 5 mL of sterile pure water was added after the seeds were placed in the Petri dishes. The germination test was laid out at 25 ± 1 °C in the dark, and the percentage of germination was measured using daily counts for 14 days. The germination papers were moistened as needed. Normal seedlings were determined at the end of the experiment.
Mean germination time (MGT) was calculated based on the daily counts made during the experimental period [52].
MGT = ∑(Gt × Dt)/∑Gt where Gt = number of seed germinated at time Dt; Dt = days from when seed germinated.
2.4. Seedling Emergence Experiment
The seedling emergence test was performed with the same protocol as the germination test (mentioned above). Seeds coated with four different endophytic bacteria and control groups were sown in vials at a depth of 1 cm in a mixture of peat and perlite (1:0.5). The vials were put in a climate-controlled chamber at 22 ± 1 °C and 60–70% relative humidity with 16 h light and 8 h dark conditions. Emergence counts were executed daily for 21 days. The seedling emergence percentages (the appearance of hypocotyls at the surface) were determined after 21 days. Mean emergence time (MET) was determined through the daily counts made during the experimental time.
2.5. Radicle Emergence Assay
RE (radicle emergence, 2 mm length) was calculated in continuous counts of radicle emergence after 72, 120, and 168 h for germination assay and hypocotyl occurrence was taken into consideration after 168, 216 and 264 h for seedling emergence experiment.
2.6. Statistical Analysis
The tests in the study were designed based on the experimental randomized parcel design with four replicates. The percentage values gained from these tests were subjected to transformation. All mean data were assessed with one-way ANOVA using the JMP 8.0 statistical package program. The means of values were compared using the Duncan Multiple Range Test at p < 0.05 level of significance.
3. Results
3.1. Efficacy of Bio-Priming with Endophytic Pseudomonas and Bacillus spp. on Seed Germination
Priming treatments of seeds notably influenced the germination characteristics, resulting in better germination percentages. There were dual statistical interactions determined between maturity levels and bio-priming treatments for germination and vigor tests. The impact of bio-priming on germination percentage changed with maturity levels (Table 1). The mean germination rate of PGPB inoculated immature seeds were 61.3%, 70.0%, 60% and 70.7% for the strains ApBm, Bs1, L5b and L13, respectively. Germination rates were higher in seeds inoculated with PGPB than in control (55.5%). However, the control (+) treatment (70.3%) statistically had the same effect as the bacterial strains Bacillus subtilis strain Bs1 and Pseudomonas gessardii strain L13 in terms of germination rate (p < 0.01). As for the mature seed lots, all the bio-primed seeds and mock-inoculated (control (+)) seeds displayed remarkably higher germination percentages compared to the control group (87.5%). As the germination test results were evaluated using maturity levels, the germination rate of mature seed lots (92.0%) was greater than the immature seeds (64.6%). When treatments were compared to each other, the effect of bio-priming with PGPB on germination percentage changed with bacteria strains (Table 1). Germination percentages were higher for bio-priming with Bacillus subtilis strain Bs1 (82.0%) and P. gessardii strain L13 (82.4%) along with control (+) group (81.9%), compared to the seeds treated with Bacillus mojavensis strain ApBm (75.9%), Pseudomonas fluorescens strain L5b (76.3%) and control seed lots (71.5%).
Table 1.
Effect of endophytic bacteria inoculation on mean germination percentages of immature and mature pepper seeds.
Priming treatments have a crucial impact on germination vigor. Mean germination time is one of the methods used to determine seed vigor. When the mean germination time of bio-primed and control seeds were examined, seed inoculation with endophytic PGPB significantly improved the speed of germination compared to both control groups (control and control (+)) at both maturity levels. Nevertheless, the rate of improvement varied with bacterial strains (Table 2). The shortest germination time was obtained with the mature pepper seed lot inoculated with the Bacillus mojavensis strain ApBm (4.01). On the other hand, the longest (6.52) mean germination time was found in the untreated control group. A similar trend was seen with the immature seed lots as well. Inoculation with the L13 strain shortened the germination time up to 1.75 days compared to the control group and 1.62 days for the control (+) group (Table 3). In terms of maturity levels, mature seed lots (5.02) germinated faster than immature pepper seeds (6.55). Among the treatments, the shortest germination time was obtained with the L13 strain (4.82). Based on the results of this experiment, bio-priming with endophytic PGPB reduced the time required for germination compared to control groups and positively affected the quality of seeds at both maturity levels (Figure 4).
Table 2.
Effect of endophytic bacteria inoculation on mean germination times of immature and mature pepper seeds.
Table 3.
Advantage table for the endophytic bacteria strains against control groups for pepper seeds.
Figure 4.
Mean germination (MGT) and seedling emergence (MET) times of bio-primed and control pepper seeds. Data Scheme 0. for the same criterion.
3.2. Influence of Bio-Priming Treatments on Seedling Emergence
Bio-priming treatment significantly influenced the seedling emergence percentages of “Kandil Dolma” pepper seeds at both maturity levels (Table 4). The mean emergence percentages of the bio-primed seeds were 69.3%, 73.0%, 69.0% and 67.0% for ApBm, Bs1, L5B and L13 immature seeds, respectively. However, these figures increased to 86.0%, 97.0%, 93.0% and 80.0% for the mature seeds according to the interaction found between maturity levels and treatments. The control and the control (+) seeds had much lower values, with 45.3% and 68.0%, and 61.0% and 65.0% for immature and mature seeds, respectively. The effect of bio-priming treatment was revealed more clearly with the seedling emergence parameters than the germination test. The gap between the control groups and bio-primed seeds was widened further by treatment with endophytic Bacillus and Pseudomonas species. For instance, inoculation with Bacillus subtilis (strain Bs1) increased emergence percentages up to 36% and 32% than the control and control (+) seeds, respectively, in mature seed lot (Table 3). All the bio-primed seeds showed better emergence rates for means values of both maturity levels.
Table 4.
Effect of endophytic bacteria inoculation on mean emergence percentages of immature and mature pepper seeds.
The treatment with bio-priming demonstrated a significantly lower emergence time than both control groups in both maturity levels. While the lowest (8.47) emergence time was found with Pseudomonas fluorescens strain L5b seeds, the highest seedling emergence time (9.36) was determined for the control group in mature seed lots (Table 5). A moderately decreased seedling emergence time was recorded from the pretreated L5B (9.43), and L13 (9.50) strains in immature seed lots, which were statistically similar. In addition, the best result was obtained from strain Bs1 (8.85) for the same maturity level (Figure 4). Seeds inoculated with the Bs1 strain had a difference of 2.01 days compared to untreated seeds and 1.21 days for the control (+) for immature seed lots (Table 3). Consequently, the results mainly indicated that, compared with control groups at both maturity levels, all the bio-priming treatments (except strain ApBm) provided statistically better outcomes in reducing the time of seedling emergence, naturally enhancing the pepper seed quality.
Table 5.
Effect of endophytic bacteria inoculation on mean emergence times of immature and mature pepper seeds.
3.3. Evaluation of Radicle Emergence (RE) Assay
In this method, the vigor of bio-primed and control seed lots at different maturity levels was measured by single early counts of radicle emergence to 2 mm at 72 h, 120 h and 168 h for the germination test and 168 h, 216 h and 264 h for the seedling emergence test. The RE test showed that the initial moment of radicle emergence varied between the seed lots. When the RE values of the germination experiment were examined, differences were observed between maturity levels. According to the data obtained by radicle counts at the 72nd hour, it was determined that the bio-primed L13 strain (5.5%) came to the fore for immature seeds; furthermore, higher results were obtained with L13 and ApBm strains (18.0% and 28.5%, respectively) compared to control and control (+) groups (4.5% and 10.0%) for mature seed lots. In parallel with the results of the 72nd hour, the L13 strain made a significant difference in immature seed lots at the 120th hour (42.5%). Moreover, clearly higher radicle emergence percentages were acquired with all bio-primed seeds (ApBm, Bs1, L5b and L13 strain) for mature seeds (81.5%, 80%, 77% and 93%, respectively) compared to both control and control (+) groups (17.5% and 42.7%). Regarding the data at 168th hour, bio-priming with endophytic bacteria accelerated germination compared to both control groups for immature seeds. However, this outcome was not detected for mature seed lots (Figure 5).
Figure 5.
Cumulative radicle emergence percentages ± SE of immature and mature pepper seeds during the germination Table 5 level.
The analysis of variance showed significant differences among the treatments and maturity levels for RE throughputs in the seedling emergence test (Figure 6). Based on the results obtained from the counts made in the 168th hour of the seedling emergence experiment, there was no statistical difference found between the treatments for mature seeds, while bio-priming with Bs1, L5b and L13 strains yielded higher emergence percentages for immature seed lots (9%, 8% and 7%, respectively). Seed inoculation with endophytic bacteria significantly elevated RE values in 216 h counts at both maturity levels. However, the rate of enhancement varied with bacterial strains. All bacteria (Bs1, L5b and L13 strain), except Bacillus mojavensis ApBm (18%), improved RE percentages (56%, 41% and 40%) compared to non-treated control (0%) and control (+) (27%) in immature seeds. Considering the measurements for mature seeds, higher radicle emergence rates were provided from all seed lots inoculated with endophytic bacteria. This case is also seen in the data taken from the same maturity level at the 264th hour. In other words, these results clearly specified that the vigor of pepper seeds at different maturity levels was affected positively by bacteria strains at the point of radicle emergence rate.
Figure 6.
Cumulative seedling emergence percentages ± SE of immature and mature pepper seeds during the emergence test. Means with different letters in the same hour indicate significant differences at the 5% level. N.S.: not significant.
4. Discussion
In the present study, bio-priming with four different endophytic bacteria elevated the vigor potential of pepper seeds compared to untreated seeds and mock-inoculated seeds. Moreover, the use of Pseudomonas gessardii strain L13 and Bacillus subtilis strain Bs1 improved germination values to a certain level at both maturity levels. Similar advances in seed germination parameters by endophytic bacteria were stated for other plants like maize [53], wheat [54] and tomato [55]. These findings can be due to the increased synthesis of phytohormones like gibberellins, cytokinin and siderophores, which launch the activity of certain enzymes that stimulate quick germination [13,56]. In addition, an important development in seedling vigor may be seen through the higher synthesis of auxins [57]. Mechanisms for better germination and breaking of dormancy with bio-priming treatment can be the initiation of water-stimulated metabolic activity, advanced fixing due to enzyme activity, production of hormones and biological control by production of siderophores [11,40].
Commercial seed production in continuously flowering pepper plants is usually carried out in a single harvest. Mainly all fruits are harvested and seeds extracted simultaneously. Due to this method preferred by seed companies, seeds with different maturity levels (immature–mature–over mature) are collected together [7]. Under these circumstances, numerous researchers reported that lower germination performance was seen in immature seeds compared to mature seeds in many crops [6,58,59,60,61]. This is the case for immature seeds that have partially less developed embryonic textures, and it is possible that inoculation with endophytic bacteria initiates embryonic development, which then lets seeds germinate quicker. Thus, the germination potential is enhanced, especially for immature seeds, which may improve the overall chance of successful stand establishment.
Our study also highlights that the beneficial endophytic bacteria strains significantly promoted the emergence of the pepper seedlings, considering the results of radicle emergence and seedling emergence assays. In these assays, inoculation with four different endophytic bacteria strains accelerated the seedling emergence period and increased the rate of emergence compared to control groups at both maturity levels. These results are similar to the findings of a few studies [14,45,47,62,63,64]. They generally concluded that inoculated seeds resulted in better germination and early seedling development. In these former works, researchers mostly utilized mature seeds in their studies; however, the current study investigated the efficiency of endophytic bacteria strains on immature seeds and mature seeds. In this respect, the study is different from other studies. The physiological reasons for the advantage obtained due to endophytes are not clear. However, there are some reports that they extend root elongation rate, root branching [65], or alter hormone levels, such as indole acetic acid (IAA) that modulate seedling growth [66]. We emphasize that some endophytes like Bacillus can be selective, as they are common in cucurbits but rare in others suggesting a selective ecological role [67]. In that sense, differences in bacteria’s effect in our work may be attributed to their species selectivity, colonization and environment combination [68].
The influence of different strains of endophytic bacteria also increased sprouting capacity to different extents depending on the strain. The most persistently performing strains to improve seedling quality were Pseudomonas fluorescens strain L5b and Pseudomonas gessardii strain L13. The improved RE values and seedling growth in response to both inoculants compared with the mock-inoculated seeds (control (+)) indicates the beneficial role of these endophytic bacteria. Several reports also demonstrated that sprouting is positively affected by various genera of PGPB, such as Pseudomonas and Bacillus [19,36,51,69]. The present results also have value for organic transplant production systems. Chemicals are not allowed in organic transplant production methods. Therefore, beneficial bacteria have benefits regarding seed quality enhancing treatments [69].
Seed germination is a complicated mechanism that is completed by the radicle’s emergence through the seed coat [70]. It is initiated with the uptake of water that raises seed weight. This increase in inner water capacity rebuilds a practical hydrophobic movement to regulate proteins and cell membranes. Mitochondria and DNA are restored for protein synthesis from stocked and freshly produced RNAs. By reducing the effectiveness of the factors that restrict germination, nutrients are spread throughout the seed to achieve goals. The radicle then appears through fast cell extension followed by a slower cell-division-induced development [71]. Earlier radicle emergence and higher seedling emergence in inoculated seeds showed that beneficial bacteria are likely to initiate faster decomposition of seed storage materials. This resulted in faster seed germination and seedling emergence. These features are valuable for obtaining well-developed transplant production in modules with vegetable seeds, including pepper [72]. Moreover, shorter mean time to germination and emergence showed that treated seeds are likely to have larger seedling size and uniformity. Some earlier studies indicated that fast germination resulted in larger seedling size and better stand establishment. However, within this mechanism, endophytic bacteria’s effect on seeds with underdeveloped embryos and encouraging their development should be investigated with further studies since seed lots with various maturity stages are very likely in once-over seed-harvesting practices.
5. Conclusions
To sum up, everything that was stated so far, priming pepper seeds with beneficial bacterial inocula is an attractive ecological approach for improving germination rates of seeds with different maturity levels. Bio-priming with Pseudomonas and Bacillus strains used in this study is potentially able to stimulate rapid and uniform germination as well as faster seedling growth. Moreover, this method is of interest and merit to companies, which demand good quality in their seeds.
Author Contributions
Conceptualization, K.C.Y.; formal analysis, K.C.Y.; investigation, K.C.Y., H.O. and M.M.G.; methodology, K.C.Y., D.C.O. and H.O.; writing—original draft, K.C.Y., D.C.O. and I.D.; writing—review and editing, K.C.Y. and I.D. All authors have read and agreed to the published version of the manuscript.
Funding
This study was funded by the Ministry of Agriculture and Forestry—Turkey. Grant number: 16/A09/P06/01.
Institutional Review Board Statement
Not applicable.
Informed Consent Statement
Not applicable.
Data Availability Statement
Not applicable.
Conflicts of Interest
The authors declare no conflict of interest.
References
- Vidigal, D.; Dias, D.; Von Pinho, E.; Dias, L. Sweet pepper seed quality and lea-protein activity in relation to fruit maturation and post-harvest storage. Seed Sci. Technol. 2009, 37, 192–201. [Google Scholar] [CrossRef]
- Demir, I.; Ellis, R.H. Development of pepper (Capsicum annuum L.) seed quality. Ann. Appl. Biol. 1992, 121, 385–399. [Google Scholar] [CrossRef]
- Demir, I.; Samit, Y. Seed quality in relation to fruit maturation and seed dry weight during development in tomato. Seed Sci. Technol. 2001, 29, 453–462. [Google Scholar]
- Vidigal, D.D.S.; Dias, D.C.F.D.S.; Dias, L.A.D.S.; Finger, F.L. Changes in seed quality during fruit maturation of sweet pepper. Sci. Agricola 2011, 68, 535–539. [Google Scholar] [CrossRef]
- Nogueira, J.L.; Da Silva, B.A.; Mógor, Á.F.; Grzybowski, C.R.D.S.; Panobianco, M. Quality of organically produced bell pepper seeds. J. Seed Sci. 2017, 39, 100–105. [Google Scholar] [CrossRef][Green Version]
- Demir, I.; Ellis, R.H. Changes in seed quality during seed development and maturation in tomato. Seed Sci. Res. 1992, 2, 81–87. [Google Scholar] [CrossRef]
- Demir, I.; Ozden, E.; Yıldırım, K.; Sahin, O.; Van Staden, J. Priming with smoke-derived karrikinolide enhances germination and transplant quality of immature and mature pepper seed lots. S. Afr. J. Bot. 2018, 115, 264–268. [Google Scholar] [CrossRef]
- Mahmood, A.; Kataoka, R. Potential of Biopriming in Enhancing Crop Productivity and Stress Tolerance. Adv. Seed Priming 2018, 127–145. [Google Scholar] [CrossRef]
- Wilson, D. Endophyte: The Evolution of a Term, and Clarification of Its Use and Definition. Oikos 1995, 73, 274. [Google Scholar] [CrossRef]
- Gond, S.K.; Bergen, M.S.; Torres, M.S.; White, J.F. Endophytic Bacillus spp. produce antifungal lipopeptides and induce host defence gene expression in maize. Microbiol. Res. 2015, 172, 79–87. [Google Scholar] [CrossRef] [PubMed]
- Truyens, S.; Weyens, N.; Cuypers, A.; Vangronsveld, J. Bacterial seed endophytes: Genera, vertical transmission and interaction with plants. Environ. Microbiol. Rep. 2015, 7, 40–50. [Google Scholar] [CrossRef]
- Herrera, S.D.; Grossi, C.; Zawoznik, M.; Groppa, M.D. Wheat seeds harbour bacterial endophytes with potential as plant growth promoters and biocontrol agents of Fusarium graminearum. Microbiol. Res. 2016, 186–187, 37–43. [Google Scholar] [CrossRef] [PubMed]
- López, S.M.Y.; Pastorino, G.N.; Franco, M.E.E.; Medina, R.; Lucentini, C.G.; Saparrat, M.C.N.; Balatti, P.A. Microbial Endophytes that Live within the Seeds of Two Tomato Hybrids Cultivated in Argentina. Agronomy 2018, 8, 136. [Google Scholar] [CrossRef]
- Verma, S.; Kingsley, K.; Irizarry, I.; Bergen, M.; Kharwar, R.; White, J. Seed-vectored endophytic bacteria modulate development of rice seedlings. J. Appl. Microbiol. 2017, 122, 1680–1691. [Google Scholar] [CrossRef]
- Compant, S.; Clément, C.; Sessitsch, A. Plant growth-promoting bacteria in the rhizo- and endosphere of plants: Their role, colonization, mechanisms involved and prospects for utilization. Soil Biol. Biochem. 2010, 42, 669–678. [Google Scholar] [CrossRef]
- Glick, B.R. Beneficial Plant-Bacterial Interactions; Springer: Heidelberg, Germany, 2015. [Google Scholar] [CrossRef]
- Mia, M.A.B.; Shamsuddin, Z.H.; Mahmood, M. Effects of rhizobia and plant growth promoting bacteria inoculation on germination and seedling vigor of lowland rice. Afr. J. Biotechnol. 2012, 11, 3758–3765. [Google Scholar] [CrossRef]
- Mitter, B.; Petric, A.; Chain, P.S.; Trognitz, F.; Nowak, J.; Compant, S.; Sessitsch, A. Genome Analysis, Ecology, and Plant Growth Promotion of Theendophyte Burkholderia Phytofirmans Strain PsJN. In Molecular Microbial Ecology of the Rhizosphere, 1st ed.; Bruijn, F.J., Ed.; John Wiley & Sons, Inc.: Hoboken, NJ, USA, 2013; pp. 865–874. [Google Scholar] [CrossRef]
- Turan, M.; Ekinci, M.; Yildirim, E.; Güneş, A.; Karagöz, K.; Kotan, R.; Dursun, A. Plant growth-promoting rhizobacteria improved growth, nutrient, and hormone content of cabbage (Brassica oleracea) seedlings. Turk. J. Agric. For. 2014, 38, 327–333. [Google Scholar] [CrossRef]
- Seghers, D.; Wittebolle, L.; Top, E.M.; Verstraete, W.; Siciliano, S.D. Impact of Agricultural Practices on the Zea mays L. Endophytic Community. Appl. Environ. Microbiol. 2004, 70, 1475–1482. [Google Scholar] [CrossRef]
- Romero, F.M.; Marina, M.; Pieckenstain, F.L. The communities of tomato (Solanum lycopersicum L.) leaf endophytic bacteria, analyzed by 16S-ribosomal RNA gene pyrosequencing. FEMS Microbiol. Lett. 2014, 351, 187–194. [Google Scholar] [CrossRef]
- Hallmann, J.; Quadt-Hallmann, A.; Mahaffee, W.F.; Kloepper, J.W. Bacterial endophytes in agricultural crops. Can. J. Microbiol. 1997, 43, 895–914. [Google Scholar] [CrossRef]
- Sturz, A.; Nowak, J. Endophytic communities of rhizobacteria and the strategies required to create yield enhancing associations with crops. Appl. Soil Ecol. 2000, 15, 183–190. [Google Scholar] [CrossRef]
- Rosenblueth, M.; Martínez-Romero, E. Bacterial Endophytes and Their Interactions with Hosts. Mol. Plant Microbe Interact. 2006, 19, 827–837. [Google Scholar] [CrossRef] [PubMed]
- Sun, Y.; Cheng, Z.; Glick, B.R. The presence of a 1-aminocyclopropane-1-carboxylate (ACC) deaminase deletion mutation alters the physiology of the endophytic plant growth-promoting bacterium Burkholderia phytofirmans PsJN. FEMS Microbiol. Lett. 2009, 296, 131–136. [Google Scholar] [CrossRef] [PubMed]
- Marquez-Santacruz, H.; Hernandez-Leon, R.; Orozco-Mosqueda, M.; Velazquez-Sepulveda, I.; Santoyo, G. Diversity of bacterial endophytes in roots of Mexican husk tomato plants (Physalis ixocarpa) and their detection in the rhizosphere. Genet. Mol. Res. 2010, 9, 2372–2380. [Google Scholar] [CrossRef]
- Shi, Y.; Yang, H.; Zhang, T.; Sun, J.; Lou, K. Illumina-based analysis of endophytic bacterial diversity and space-time dynamics in sugar beet on the north slope of Tianshan mountain. Appl. Microbiol. Biotechnol. 2014, 98, 6375–6385. [Google Scholar] [CrossRef]
- Callan, N.W.; Mathre, D.E.; Miller, J.B. Field Performance of Sweet Corn Seed Bio-primed and Coated with Pseudomonas fluorescens AB254. HortScience 1991, 26, 1163–1165. [Google Scholar] [CrossRef]
- Bennett, A.J.; Mead, A.; Whipps, J.M. Performance of carrot and onion seed primed with beneficial microorganisms in glasshouse and field trials. Biol. Control 2009, 51, 417–426. [Google Scholar] [CrossRef]
- Chakraborty, A.P.; Dey, P.; Chakraborty, B. Plant growth promotion and amelioration of salinity stress in crop plants by a salt-tolerant bacterium. Recent Res. Sci. Technol. 2011, 3, 61–70. [Google Scholar]
- Gururani, M.A.; Upadhyaya, C.P.; Baskar, V.; Venkatesh, J.; Nookaraju, A.; Park, S.W. Plant Growth-Promoting Rhizobacteria Enhance Abiotic Stress Tolerance in Solanum tuberosum Through Inducing Changes in the Expression of ROS-Scavenging Enzymes and Improved Photosynthetic Performance. J. Plant Growth Regul. 2013, 32, 245–258. [Google Scholar] [CrossRef]
- Mirshekari, B.; Hokmalipour, S.; Sharifi, R.S.; Farahvash, F.; Gadim, A. Effect of seed biopriming with plant growth promoting rhizobacteria (PGPR) on yield and dry matter accumulation of spring barley (Hordeum vulgare L.) at various levels of nitrogen and phosphorus fertilizers. J. Food Agric. Environ. 2012, 10, 314–320. [Google Scholar]
- Sharifi, R.S. Study of nitrogen rates effects and seed biopriming with PGPR on quantitative and qualitative yield of Safflower (Carthamus tinctorius L.). Tech. J. Eng. Appl. Sci. 2012, 2, 162–166. [Google Scholar]
- Noumavo, P.A.; Kochoni, E.; Didagbé, Y.O.; Adjanohoun, A.; Allagbé, M.; Sikirou, R.; Gachomo, E.W.; Kotchoni, S.O.; Baba-Moussa, L. Effect of Different Plant Growth Promoting Rhizobacteria on Maize Seed Germination and Seedling Development. Am. J. Plant Sci. 2013, 4, 1013–1021. [Google Scholar] [CrossRef]
- Rozier, C.; Hamzaoui, J.; Lemoine, D.; Czarnes, S.; Legendre, L. Field-based assessment of the mechanism of maize yield enhancement by Azospirillum lipoferum CRT1. Sci. Rep. 2017, 7, 1–12. [Google Scholar] [CrossRef]
- Lastochkina, O.; Garshina, D.; Ivanov, S.; Yuldashev, R.; Khafizova, R.; Allagulova, C.; Fedorova, K.; Avalbaev, A.; Maslennikova, D.; Bosacchi, M. Seed Priming with Endophytic Bacillus subtilis Modulates Physiological Responses of Two Different Triticum aestivum L. Cultivars under Drought Stress. Plants 2020, 9, 1810. [Google Scholar] [CrossRef]
- Yildirim, E.; Turan, M.; Donmez, M.F. Mitigation of salt stress in radish (Raphanus sativus L.) by plant growth promoting rhizobacteria. Romanian Biotec. Lett. 2008, 13, 3933–3943. [Google Scholar]
- Prasad, S.R.; Kamble, U.R.; Sripathy, K.V.; Bhaskar, K.U.; Singh, D.P. Seed Bio-Priming for Biotic and Abiotic Stress Management. In Microbial Inoculants in Sustainable Agricultural Productivity; Singh, D.P., Singh, H.B., Prabha, R., Eds.; Vol. 1: Research Perspectives; Springer: New Delhi, India, 2016; Volume 1, pp. 211–228. [Google Scholar]
- Ertan, Y.; Metin, T.; Melek, E.; Atilla, D.; Ramazan, C.; Yildirim, E.; Turan, M.; Ekinci, M.; Dursun, A.; Cakmakci, R. Plant growth promoting rhizobacteria ameliorate deleterious effect of salt stress on lettuce. Sci. Res. Essays 2011, 6, 4389–4396. [Google Scholar] [CrossRef]
- Walitang, D.I.; Kim, K.; Madhaiyan, M.; Kim, Y.K.; Kang, Y.; Munusamy, M. Characterizing endophytic competence and plant growth promotion of bacterial endophytes inhabiting the seed endosphere of Rice. BMC Microbiol. 2017, 17, 1–13. [Google Scholar] [CrossRef] [PubMed]
- Rodríguez, C.E.; Antonielli, L.; Mitter, B.; Trognitz, F.; Sessitsch, A. Heritability and Functional Importance of the Setaria viridis Bacterial Seed Microbiome. Phytobiomes J. 2020, 4, 40–52. [Google Scholar] [CrossRef]
- Rochefort, A.; Briand, M.; Marais, C.; Wagner, M.-H.; Laperche, A.; Vallée, P.; Barret, M.; Sarniguet, A. Influence of Environment and Host Plant Genotype on the Structure and Diversity of the Brassica napus Seed Microbiota. Phytobiomes J. 2019, 3, 326–336. [Google Scholar] [CrossRef]
- Barret, M.; Briand, M.; Bonneau, S.; Préveaux, A.; Valière, S.; Bouchez, O.; Hunault, G.; Simoneau, P.; Jacquesa, M.-A. Emergence Shapes the Structure of the Seed Microbiota. Appl. Environ. Microbiol. 2015, 81, 1257–1266. [Google Scholar] [CrossRef]
- Yang, L.; Danzberger, J.; Schöler, A.; Schröder, P.; Schloter, M.; Radl, V. Dominant Groups of Potentially Active Bacteria Shared by Barley Seeds become Less Abundant in Root Associated Microbiome. Front. Plant Sci. 2017, 8, 1005. [Google Scholar] [CrossRef] [PubMed]
- Mitter, B.; Pfaffenbichler, N.; Flavell, R.; Compant, S.; Antonielli, L.; Petric, A.; Berninger, T.; Naveed, M.; Sheibani-Tezerji, R.; Von Maltzahn, G.; et al. A New Approach to Modify Plant Microbiomes and Traits by Introducing Beneficial Bacteria at Flowering into Progeny Seeds. Front. Microbiol. 2017, 8, 11. [Google Scholar] [CrossRef] [PubMed]
- Torres-Cortés, G.; Bonneau, S.; Bouchez, O.; Genthon, C.; Briand, M.; Jacques, M.-A.; Barret, M. Functional Microbial Features Driving Community Assembly During Seed Germination and Emergence. Front. Plant Sci. 2018, 9, 902. [Google Scholar] [CrossRef] [PubMed]
- Rozier, C.; Gerin, F.; Czarnes, S.; Legendre, L. Biopriming of maize germination by the plant growth-promoting rhizobacterium Azospirillum lipoferum CRT1. J. Plant Physiol. 2019, 237, 111–119. [Google Scholar] [CrossRef]
- Chesneau, G.; Torres-Cortes, G.; Briand, M.; Darrasse, A.; Preveaux, A.; Marais, C.; Jacques, M.-A.; Shade, A.; Barret, M. Temporal dynamics of bacterial communities during seed development and maturation. FEMS Microbiol. Ecol. 2020, 96, 190. [Google Scholar] [CrossRef]
- International Center for Agricultural Research in the Dry Areas (ICARDA). Methods of Soil, Plant, and Water Analysis: A Manual for the West Asia and North Africa Region, 3rd ed.; Estefan, G., Sommer, R., Ryan, J., Eds.; ICARDA: Beirut, Lebanon, 2013; pp. 61–133. [Google Scholar]
- ISTA. International Rules for Seed Testing; Edition 2016; International Seed Testing Association: Bassersdorf, Switzerland, 2016. [Google Scholar]
- Orel, D.C. Biocontrol of bacterial diseases with beneficial bacteria in lettuce. Int. J. Agric. Nat. Sci. 2020, 13, 108–117. [Google Scholar]
- Ellis, R.H.; Roberts, E.H. Towards a Rational Basis for Seed Testing in Seed Production; Hebblethwaite, P.D., Ed.; Butterworths: London, UK, 1980; pp. 605–635. [Google Scholar]
- Rozier, C.; Erban, A.; Hamzaoui, J.; Prigent-Combaret, C.; Comte, G.; Kopka, J.; Czarnes, S.; Legendre, L. Xylem Sap Metabolite Profile Changes during Phytostimulation of Maize by the Plant Growth-Promoting Rhizobacterium, Azospirillum lipoferum CRT1. Metabolomics 2016, 6. [Google Scholar] [CrossRef]
- Khan, M.Y.; Zahir, Z.A.; Asghar, H.N.; Waraich, E.A. Preliminary investigations on selection of synergistic halotolerant plant growth promoting rhizobacteria for inducing salinity tolerance in wheat. Pak. J. Bot. 2017, 49, 1541–1551. [Google Scholar]
- Koohakan, P.; Prasom, P.; Sikhao, P. Application of seed coating with endophytic bacteria for Fusarium wilt disease reduction and growth promotion in tomato. Int. J. Agric. Technol. 2020, 16, 55–62. [Google Scholar]
- Naveed, M.; Mitter, B.; Yousaf, S.; Pastar, M.; Afzal, M.; Sessitsch, A. The endophyte Enterobacter sp. FD17: A maize growth enhancer selected based on rigorous testing of plant beneficial traits and colonization characteristics. Biol. Fertil. Soils 2014, 50, 249–262. [Google Scholar] [CrossRef]
- Bharathi, R.; Vivekananthan, R.; Harish, S.; Ramanathan, A.; Samiyappan, R. Rhizobacteria-based bio-formulations for the management of fruit rot infection in chillies. Crop. Prot. 2004, 23, 835–843. [Google Scholar] [CrossRef]
- Welbaum, G.E. Cucurbit Seed Development and Production. HortTechnology 1999, 9, 341–348. [Google Scholar] [CrossRef]
- Kenanoglu, B.B.; Demir, I.; Jalink, H. Chlorophyll Fluorescence Sorting Method to Improve Quality of Capsicum Pepper Seed Lots Produced from Different Maturity Fruits. HortScience 2013, 48, 965–968. [Google Scholar] [CrossRef]
- Dos Santos, H.O.; Dutra, S.M.F.; Raquel, R.W.P.; Pires, M.O.; von Pinho, É.V.R.; da Rosa, S.D.V.F.; de Carvalho, M.L.M. Physiological quality of habanero pepper (Capisicum chinense) seeds based on development and drying process. Afr. J. Agric. Res. 2016, 11, 1102–1109. [Google Scholar] [CrossRef]
- Ellis, R.H. Temporal patterns of seed quality development, decline, and timing of maximum quality during seed development and maturation. Seed Sci. Res. 2019, 29, 135–142. [Google Scholar] [CrossRef]
- Moeinzadeh, A.; Sharif-Zadeh, F.; Ahmadzadeh, M.; Heidari Tajabadi, F. Biopriming of sunflower (Helianthus annuus L.) seed with Pseudomonas fluorescens for improvement of seed invigoration and seedling growth. Aust. J. Crop Sci. 2010, 4, 564–570. [Google Scholar]
- Zulueta-Rodríguez, R.; Hernández-Montiel, L.G.; Murillo-Amador, B.; Rueda-Puente, E.O.; Capistrán, L.L.; Troyo-Diéguez, E.; Cordoba-Matson, M.V. Effect of Hydropriming and Biopriming on Seed Germination and Growth of Two Mexican Fir Tree Species in Danger of Extinction. Forests 2015, 6, 3109–3122. [Google Scholar] [CrossRef]
- Rehman, A.; Farooq, M.; Naveed, M.; Nawaz, A.; Shahzad, B. Seed priming of Zn with endophytic bacteria improves the productivity and grain biofortification of bread wheat. Eur. J. Agron. 2018, 94, 98–107. [Google Scholar] [CrossRef]
- White, J.F.; Kingsley, K.L.; Kowalski, K.P.; Irizarry, I.; Micci, A.; Soares, M.A.; Bergen, M.S. Disease protection and allelopathic interactions of seed-transmitted endophytic pseudomonads of invasive seed grass (Phragmites australis). Plant Soil 2017, 422, 195–208. [Google Scholar] [CrossRef]
- Bacon, C.W.; White, J.F. Functions, mechanisms and regulation of endophytic and epiphytic microbial communities of plants. Symbiosis 2015, 68, 87–98. [Google Scholar] [CrossRef]
- Khalaf, E.M.; Raizada, M.N. Taxonomic and functional diversity of cultured seed associated microbes of the cucurbit family. BMC Microbiol. 2016, 16, 1–16. [Google Scholar] [CrossRef] [PubMed]
- Hardoim, P.R.; Hardoim, C.C.P.; Van Overbeek, L.S.; Van Elsas, J.D. Dynamics of Seed-Borne Rice Endophytes on Early Plant Growth Stages. PLoS ONE 2012, 7, e30438. [Google Scholar] [CrossRef]
- Ishak, Z.; Mohd Iswadi, M.K.; Russman Nizam, A.H.; Ahmad Kamil, M.J.; Ernie Eileen, R.R.; Wan Syaidatul, A.; Ainon, H. Plant growth hormones produced by endophytic Bacillus subtilis strain LKM-BK isolated from cocoa. Malays. Cocoa J. 2016, 9, 127–133. [Google Scholar]
- Bewley, J.D. Seed Germination and Dormancy. Plant Cell 1997, 9, 1055–1066. [Google Scholar] [CrossRef] [PubMed]
- Nonogaki, H.; Bassel, G.W.; Bewley, J.D. Germination—Still a mystery. Plant Sci. 2010, 179, 574–581. [Google Scholar] [CrossRef]
- Demir, I.; Ermis, S.; Mavi, K.; Matthews, S. Mean germination time of pepper seed lots (Capsicum annuum L.) predicts size and uniformity of seedlings in germination tests and transplant modules. Seed Sci. Technol. 2008, 36, 21–30. [Google Scholar] [CrossRef]
Publisher’s Note: MDPI stays neutral with regard to jurisdictional claims in published maps and institutional affiliations. |
© 2021 by the authors. Licensee MDPI, Basel, Switzerland. This article is an open access article distributed under the terms and conditions of the Creative Commons Attribution (CC BY) license (https://creativecommons.org/licenses/by/4.0/).